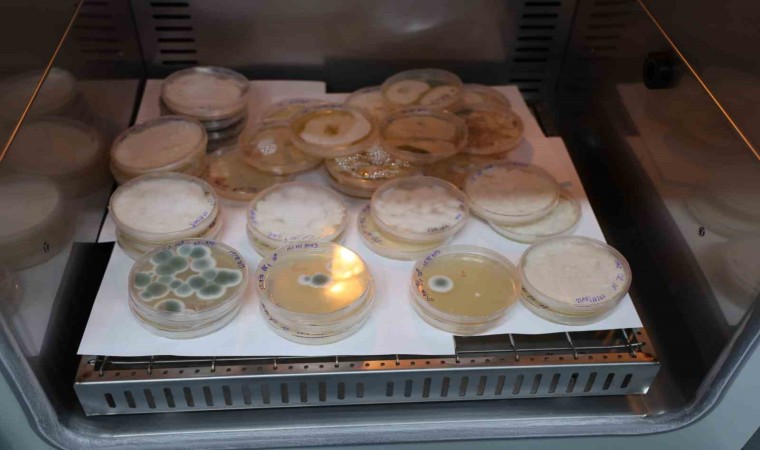

Sivas Bilim ve Teknoloji Üniversitesinde geliştirilen soğuk ve hastalıklara dirençli buğday tohumlarıyla verim 3 kat arttırması bekleniyor, Türk bilim adamlarının geliştirdiği tohumlar dünyayı bekleyen açlık tehdidine çözüm olacak.
Sivas Bilim ve Teknoloji Üniversitesi (SBTÜ), bir dönem dünya genelinde büyük krize yol açan tahıl problemine ve dünyayı beklediği iddia edilen açlık tehdidine karşı bitki ıslahı projesi yürütüyor. Toplam 250 dekarlık Tarımsal Ar-Ge Merkezinde 3 bin 500 adet tahıl çeşit adayını geliştiren akademisyenler, çeşit adaylarının performanslarını belirleyerek verim ve kalite bakımından üstün, yöreye uygun olanları seçiyor. Yapılan çalışmalar çerçevesinde 1 dönümde elde edilen ürün miktarında 3 katlık bir artış sağlanacak.
İklim ve arazi şartlarına en uygun çeşit adayları belirleyen akademisyenler, tahılların tescilini alarak çiftçilere sunacak. Sunulacak olan tahıl adayları ile birlikte çiftçilerin üretimi artarken ülke ekonomisine de katkı sunulacak.
Tarımsal Ar-Ge Merkezi ile ilgili bilgiler veren Sivas Bilim ve Teknoloji Üniversitesi (SBTÜ) Rektör Yardımcısı ve Tarım Bilimleri ve Teknoloji Fakültesi Dekanı Prof. Dr. Tolga Karaköy, “SBTÜ, Tarım Bilimleri ve Teknoloji Fakültesi Tarımsal Ar-Ge Merkezimizde farklı ürün gruplarında ıslah çalışmaları yürütüyoruz. Bu ıslah çalışmaları kapsamında yeni çeşitlerin geliştirilerek daha kaliteli, verim potansiyeli daha yüksek çeşitleri geliştirerek çiftçimizin hizmetine sunulması ve çiftçimizin gelir düzeyinin yükseltilmesi adına çalışmalarımız sürüyor. Öncelikli hedefimiz tahıllar. Buğday, arpa, yulaf gibi ürünlerin yanı sıra bölgemizde şeker pancarı ve patatese alternatif olabileceğini düşündüğümüz soya fasulyesi gibi çeşit adaylarımız var. Bu çeşit adaylarımızı tescile sunabilecek haldeyiz. Yöremizde verim potansiyeli ve kalitesi yüksek ürünler yetiştirmek istiyoruz. Bunun yanında sanayi ile de ortak çalışıyoruz. Un fabrikaları kalite, enerji ve protein değeri yüksek olan aday çeşitlerine ihtiyacı olduğunu söylüyorlar. Biz de bunlara yönelik ıslah çalışmalarımızı başlatıyoruz. Ebeveynler seçerek melezlemeler yapıyoruz. Melezlemelerin ardından laboratuvarlarımızı kullanarak ıslah sürecini hızlandırıyoruz. Islah süreci 1,2,3 yıl diye düşünülmemeli. Islah süreci fakültemiz var olduğu sürece devam edecek. Bu ıslah sürecini bizden sonraki hocalarımızın devam edeceği şekilde planladık. Bu planlarımız dâhilinde tahıllar, baklagiller, endüstri bitkileri ve yem bitkileri gibi birçok üründe ıslah çalışmalarımızı yürütüyoruz” ifadelerine yer verdi.
Çiftçilerin üretim miktarının artırılması hedefleniyor
Yapılan çalışmanın ülke ve çiftçi ekonomisine büyük katkı sağlayacağını ifade eden Prof. Dr. Tolga Karaköy, “Çiftçimize alternatif ürünler sunacağız. Alternatif ürünler konusunda da toprağın verimliliğini korumuş olacağız, çiftçimize de toprak analizi yaptırma alışkanlığını da kazandırmış olacağız. Üniversitemiz olarak çiftçilerimizle sürekli iletişim halindeyiz. Paydaşlarımızı çok önemsiyoruz, tarımsal paydaşlarımızla beraber hareket ediyoruz. Bölgenin ve yörenin sorunlarını ve sanayicinin bizden ne istediğini bilerek ayrıca çiftçimizin kendisine yönelik ürünleri üretmesini sağlayarak önce yöremize sonra ülkemize katma değer sağlayacak çalışmaları süreklilik halinde devam ettiriyoruz. Sayımız şu anda tahıl grubundan 3 bin 500. Bu rakam melezlemelerle birlikte 4 bin, 5 bin rakamlarına ulaşacak. Ürün gruplarımızın tamamında 3 bin, 5 bin veya 7 bin bitkiyle de çalışma imkânına sahibiz ve çalışıyoruz. Çiftçilerimiz geleneksel tarım uyguluyorlar. Atadan dededen gelen yöntemleri uyguluyor. Ayrıca belirli çeşitler üzerinde üretim yapılıyor. Yöremizde 3-5 çeşidi geçmiyor. Bu çeşitler zamanında ülkemize katkılar sağlamış ama artık daha verimli ve kaliteli çeşitler üzerine gitmeliyiz. Çiftçimiz daha verimli ve kaliteli çeşitler yetiştirdiği takdirde dekara 400, 500, yerine göre 700, 800 kilogram alınabilir. Çiftçilerimize bu şekilde yeni çeşitleri sunalım, hem çiftçilerimizin gelir düzeyi hem de bizim üretim potansiyelimiz artsın” diye konuştu.

Yorum Yazın
E-posta hesabınız sitede yayımlanmayacaktır. Gerekli alanlar * ile işaretlenmişdir.